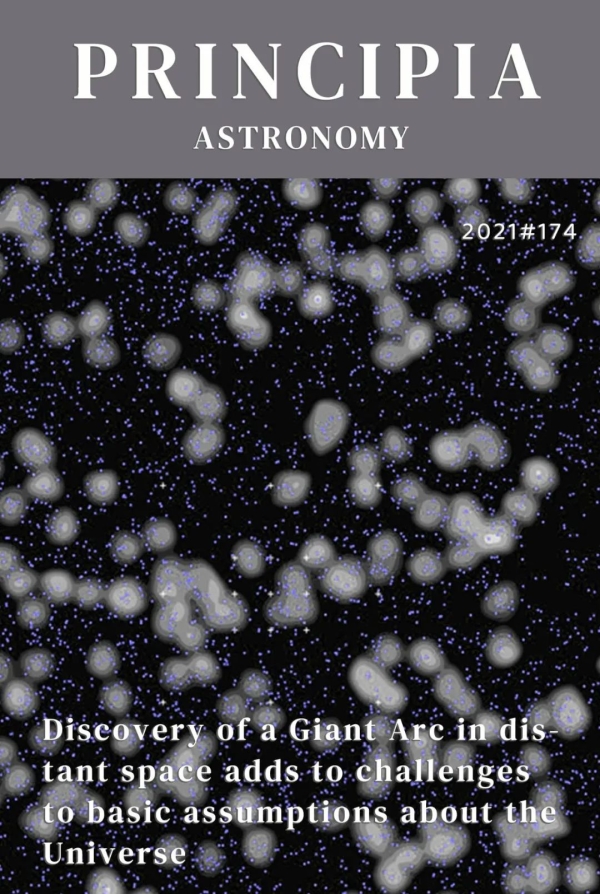

太空深处出现了一些奇怪的东西,它不是外星人。
在92亿光年之外的地方发现了一个巨大的、几乎对称的由星系构成的弧形结构。巨弧星系就像它听起来的那样——一个横跨33亿光年、宽3300亿光年的星系——如果没有类星体的帮助,它可能仍然隐藏在黑暗中。

类星体是宇宙中最亮的天体之一。超过10亿太阳质量的超大质量黑洞消耗物质并释放能量,但类星体的光不是来自黑洞本身,光不能从黑洞中逃脱,而是它的吸积盘,它充满了发光的恒星物质。围绕黑洞缓慢旋转的尘埃和气体会受到摩擦的作用,并产生大量的热量和光,为类星体提供动力。
由于这些类星体与我们相距十分遥远,因此看起来它们就像是一个个的光点。类星体释放出的光在前往地球的途中,一些光线会被遇到的星系内及其周围的原子所吸收,从而在光线中留下特定的特征,再最终抵达天文学家的望远镜中。
英国中央兰开夏大学的研究人员Alexia Lopez所在团队一直在研究类星体的数据,利用这种方法,他们描绘出了一条巨大的、近乎对称的曲线。这条曲线位于牧夫座,形状呈新月形结构,宽度跨越了33亿光年,覆盖了几十个星系,跨度约为可观测宇宙半径的1/15。根据目前的宇宙学来看,宇宙中大尺度结构的理论极限是12亿光年。也就是说,巨弧的跨度几乎是极限的3倍,也是斯隆巨壁的两倍大。她和她的研究团队最近在美国天文学会第238次会议上展示了他们的发现。
Alexia Lopez在接受采访时表示,这个巨弧线会是多么令人印象深刻,“我认为我们差点忽略了它。从视觉上看,这似乎非常有趣,但直到我们开始进行统计测试,才能够意识到巨弧的意义。”
这个神秘的巨弧是如何形成的,这是个谜,但它的存在颠覆了宇宙学原理。宇宙学原理是,从任何地方观察宇宙的物理时,宇宙的物理方面是相同的,并且是由相同的东西构成的。无论我们把望远镜瞄准哪里,我们都应该看到同样的物体。虽然在恒星系统、星系和星系团层面上或许有一些不均匀的地方,但当我们在10亿光年甚至更大的大尺度观测宇宙时,宇宙中的物质在可观测空间内应该是均匀分布的,不应该出现明显的不规则特征。

宇宙学的标准模型要如何解释这些陆续被发现的超过了理论极限的大尺度结构呢?是罕见的巧合?又或者说其背后有可能蕴含着别的秘密?在这项研究中,研究人员总共进行了三次统计计算,以试图计算出星系是偶然排成巨弧的几率。这三次测试都表明这个结构是真实存在的。
“现在用我们目前的标准模型,很难解释巨弧是如何形成的,”Lopez说。“它的发现可能使人们需要研究其他宇宙学模型和其他理论。这个结果对于理解宇宙的进展很重要。”
(独家编译:科幻世界)
最热文章

人工智能写科幻小说,和作家写科幻小说有什么不一样?

德国概念设计师Paul Siedler的场景创作,宏大气派。

《静音》是一部 Netflix 电影。尽管 Netflix 过去一年在原创电影上的表现并不如预期,但是《静音》仍让人颇为期待

最近,美国最大的经济研究机构——全国经济研究所(NBER,全美超过一半的诺奖经济学得主都曾是该机构的成员)发布了一份报告,全面分析了 1990 到 2007 年的劳动力市场情况。\n

坏机器人制片公司最新的一部电影名为《霸主》(overlord),背景设置在二战时期,很可能是一部在半遮半掩中秘密制作的科洛弗电影系列。

我们都知道,到处都在重启;我们也知道,如果有钱,啥都能重启。所以,会不会被重启算不上是个问题,只能问什么时候会被重启。自然而然地,世界各地的各种重启现象衍生出了一个有趣的猜猜游戏:哪一部老作品会是下一个接受这种待遇的?\n
 京公网安备11010502039775号
京公网安备11010502039775号